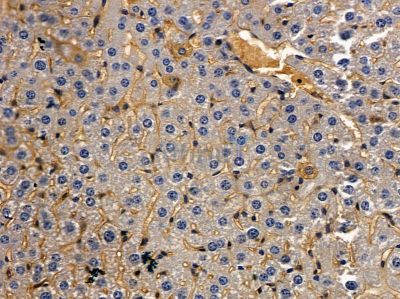
TCR beta Antibody - DF8621 at 1/100 staining mouse liver tissue by IHC-P.

TCR beta Antibody - #DF8621
| Product: | TCR beta Antibody |
| Catalog: | DF8621 |
| Description: | Rabbit polyclonal antibody to TCR beta |
| Application: | WB IHC IF/ICC |
| Reactivity: | Human, Mouse |
| Mol.Wt.: | 19 kDa; 20kD(Calculated). |
| Uniprot: | P01850 |
| RRID: | AB_2841825 |
Product Info
*The optimal dilutions should be determined by the end user. For optimal experimental results, antibody reuse is not recommended.
*Tips:
WB: For western blot detection of denatured protein samples. IHC: For immunohistochemical detection of paraffin sections (IHC-p) or frozen sections (IHC-f) of tissue samples. IF/ICC: For immunofluorescence detection of cell samples. ELISA(peptide): For ELISA detection of antigenic peptide.
Cite Format: Affinity Biosciences Cat# DF8621, RRID:AB_2841825.
Fold/Unfold
TRBC1;
Immunogens
A synthesized peptide derived from human TCR beta, corresponding to a region within the internal amino acids.
- P01850 TRBC1_HUMAN:
- Protein BLAST With
- NCBI/
- ExPASy/
- Uniprot
DLNKVFPPEVAVFEPSEAEISHTQKATLVCLATGFFPDHVELSWWVNGKEVHSGVSTDPQPLKEQPALNDSRYCLSSRLRVSATFWQNPRNHFRCQVQFYGLSENDEWTQDRAKPVTQIVSAEAWGRADCGFTSVSYQQGVLSATILYEILLGKATLYAVLVSALVLMAMVKRKDF
Research Backgrounds
Constant region of T cell receptor (TR) alpha chain. Alpha-beta T cell receptors are antigen specific receptors which are essential to the immune response and are present on the cell surface of T lymphocytes. Recognize peptide-major histocompatibility (MH) (pMH) complexes that are displayed by antigen presenting cells (APC), a prerequisite for efficient T cell adaptive immunity against pathogens. Binding of alpha-beta TR to pMH complex initiates TR-CD3 clustering on the cell surface and intracellular activation of LCK that phosphorylates the ITAM motifs of CD3G, CD3D, CD3E and CD247 enabling the recruitment of ZAP70. In turn, ZAP70 phosphorylates LAT, which recruits numerous signaling molecules to form the LAT signalosome. The LAT signalosome propagates signal branching to three major signaling pathways, the calcium, the mitogen-activated protein kinase (MAPK) kinase and the nuclear factor NF-kappa-B (NF-kB) pathways, leading to the mobilization of transcription factors that are critical for gene expression and essential for T cell growth and differentiation. The T cell repertoire is generated in the thymus, by V-(D)-J rearrangement. This repertoire is then shaped by intrathymic selection events to generate a peripheral T cell pool of self-MH restricted, non-autoaggressive T cells. Post-thymic interaction of alpha-beta TR with the pMH complexes shapes TR structural and functional avidity.
Cell membrane.
The connecting peptide (CP) domain is essential for signal transmission in response to antigenic stimulation, likely downstream from ZAP70 recruitment.
The TM domain mediates the interaction with the CD3 subunits.
Restrictive clause
Affinity Biosciences tests all products strictly. Citations are provided as a resource for additional applications that have not been validated by Affinity Biosciences. Please choose the appropriate format for each application and consult Materials and Methods sections for additional details about the use of any product in these publications.
For Research Use Only.
Not for use in diagnostic or therapeutic procedures. Not for resale. Not for distribution without written consent. Affinity Biosciences will not be held responsible for patent infringement or other violations that may occur with the use of our products. Affinity Biosciences, Affinity Biosciences Logo and all other trademarks are the property of Affinity Biosciences LTD.